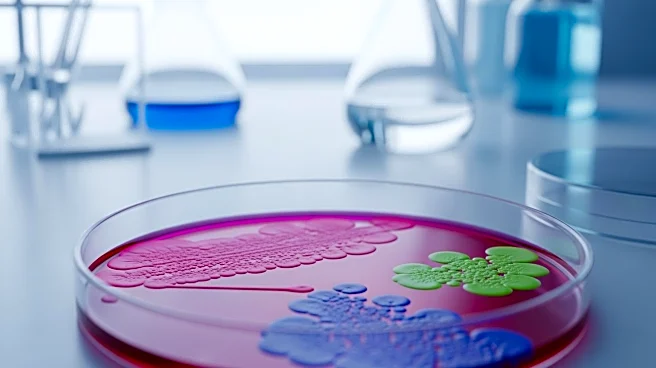
Study Reveals Rapid Evolution in Gut Bacteria Due to Modern Diets

What's Happening?
NPR has released a list of ten films from 2025 that stand out as passion projects, showcasing the power of cinema to evoke strong emotions and engage audiences. These films, including titles like 'One Battle After Another', 'The Secret Agent', and 'Frankenstein', are noted for their diverse perspectives and bold storytelling. The list highlights how these films differ from typical blockbusters by focusing on artistic expression and historical narratives, aiming to resonate deeply with viewers. The selection underscores the importance of films that take creative risks and address complex themes, offering audiences a chance to experience cinema that challenges and inspires.
Why It's Important?
The emphasis on passion projects in film highlights a shift in the industry
towards valuing artistic integrity and storytelling over commercial success. This trend can influence filmmakers to pursue more meaningful and innovative projects, potentially leading to a richer cinematic landscape. For audiences, it means access to films that offer more than just entertainment, providing thought-provoking content that can spark discussions and reflections on societal issues. The recognition of these films by a major outlet like NPR also suggests a growing appreciation for diverse voices and narratives in cinema, which can contribute to a more inclusive and representative film industry.